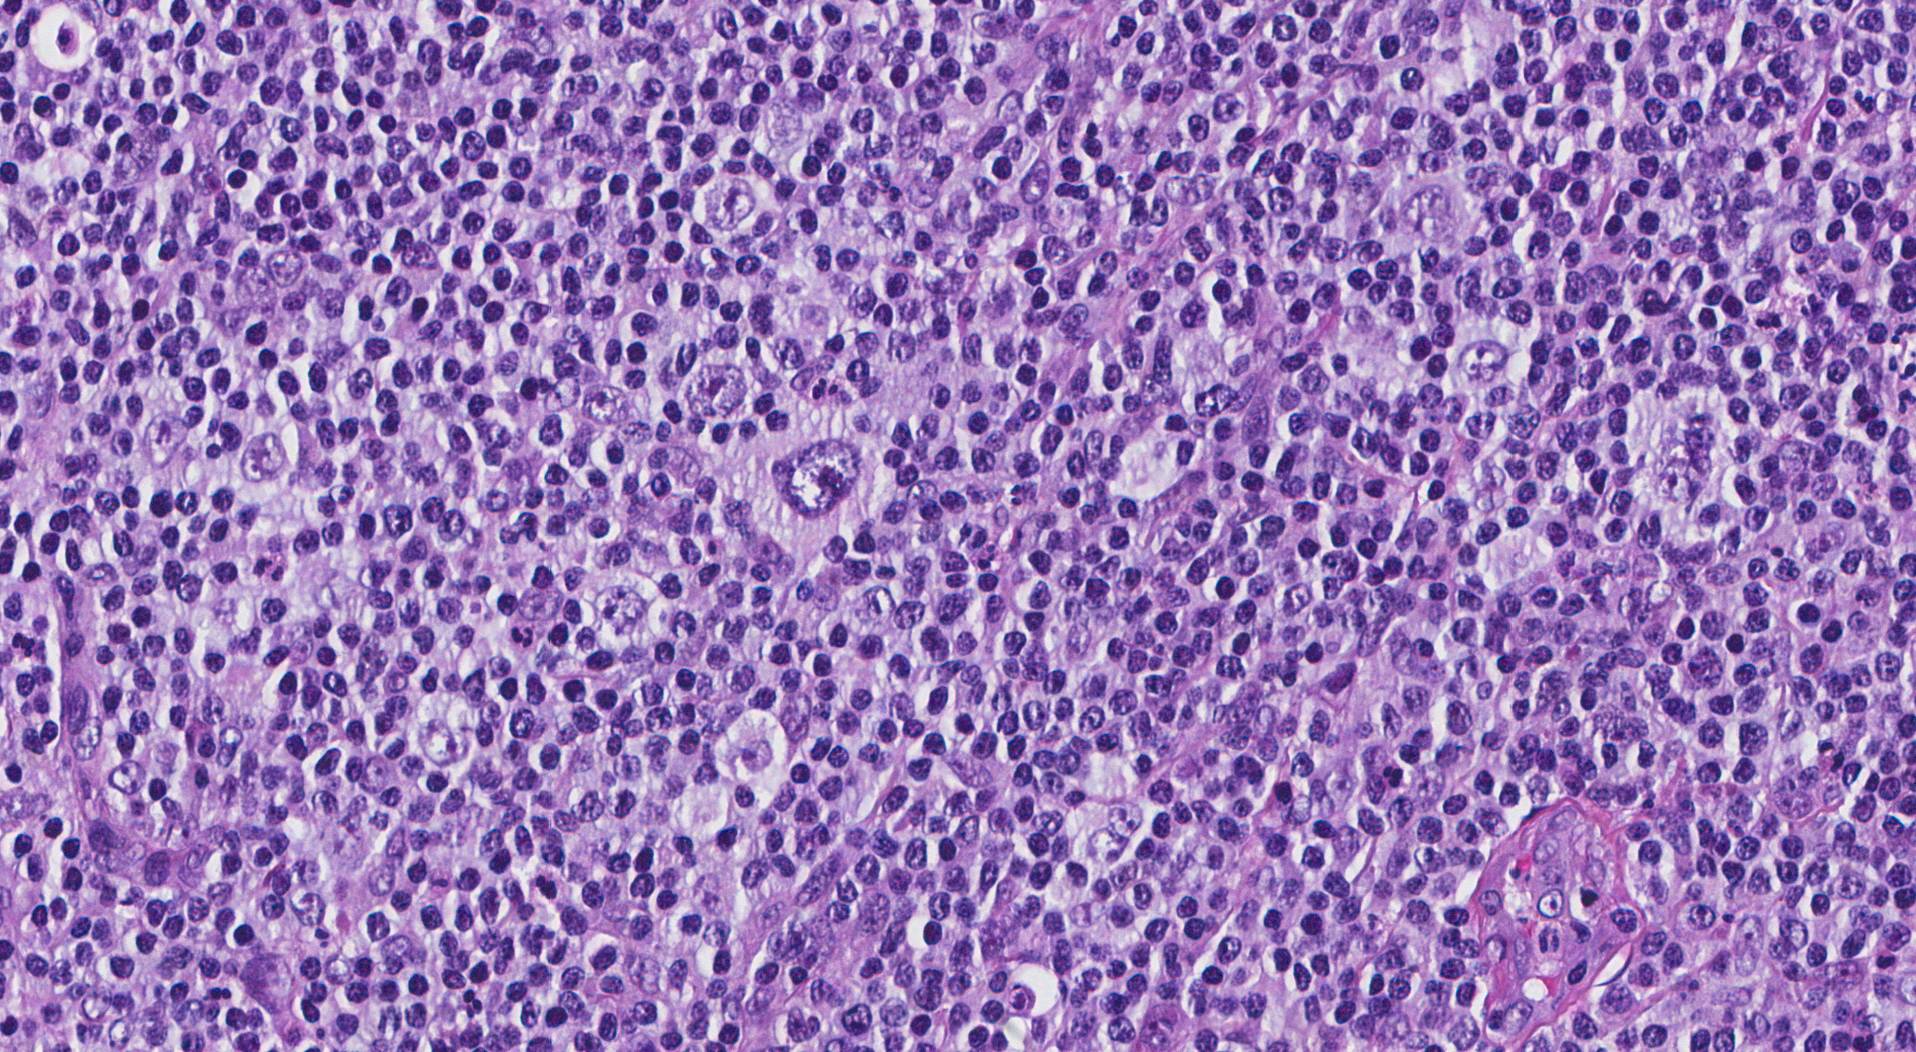
防止

リンパ球豊富なホジキンリンパ腫 (LRHL) は、リンパ系のがんであるホジキンリンパ腫のサブタイプです。
ホジキンリンパ腫 (HL) は、リンパ系に影響を及ぼすがんです。体の免疫システムのこの重要な部分は、健康を維持し、病気から守るのに役立ちます。
HL は B リンパ球の異常な増殖を引き起こします。その結果、これらの白血球がリンパ節に集まり、リンパ節が腫れます。また、免疫システムが低下しているため、感染症のリスクも高くなります。
LRHL は古典的 HL (CHL) のサブタイプで、HL 患者の約 5% を占めます。影響を受けたリンパ節には、典型的なリンパ球または小型のリンパ球と、2 つ以上の核を持つ巨大な異常なリンパ球であるリード・シュテルンバーグ細胞が含まれています。
この記事では、LRHL、その症状、原因、治療法について説明します。
LRHL は CHL のサブタイプであり、リンパ球の数が多いことが特徴です。他の形態の CHL では、リード・スタンバーグ細胞の存在は通常、健康なリンパ球の不足を意味します。しかし、LRHL では、これらの異常細胞が大量のリンパ球とともに出現し、強力な免疫反応が示唆されます。
LRHL は他の CHL サブタイプに比べて比較的まれですが、医師は早期の段階で LRHL を診断することが多いため、見通しは良好である可能性があります。
古典的ホジキンリンパ腫とは何ですか?
CHL は HL の最も一般的な形態であり、HL 患者の 95% を占めます。 CHL の特徴は、リード・スタンバーグ細胞の存在です。
CHL には 4 つの異なるサブタイプがあり、それぞれに特定の機能と発達パターンがあります。これらのサブタイプには次のものが含まれます。
- 結節性硬化症:これは最も頻繁に診断されるサブタイプであり、リンパ節内の硬化または瘢痕組織形成で注目されます。
- 混合細胞性:多くのリード-シュテルンバーグ細胞を含む、影響を受けたリンパ節内の細胞の多様な混合を特徴とします。
- リンパ球が豊富:高濃度のリンパ球を特徴とし、強力な免疫応答を示します。
- リンパ球枯渇:最もまれな形態で、リンパ球の不足と多くのリード・シュテルンバーグ細胞が特徴です。
ホジキンリンパ腫について詳しくは、こちらをご覧ください。
LRHLでは「B症状」はまれです。このグループの症状は他のタイプの HL によく見られ、発熱、寝汗、6 か月にわたる体重の 10% 以上の減少を指します。
ただし、LRHL では、首、脇の下、または鼠径部のリンパ節が腫れているものの、痛みはなく、極度の疲労感を感じることがあります。
LRHL を示す可能性のある症状が持続する場合は、医師の診察を受ける必要があります。
疲労やリンパ節の腫れは、その人がHLを患っていることを意味するものではありませんが、医師は潜在的な問題を除外するためにそれらを評価する必要があります。
LRHL の早期発見は、効果的な治療と転帰の改善にとって非常に重要です。
他のタイプのHLと同様に、LRHLの正確な原因は不明のままです。しかし、専門家は、遺伝的素因、ウイルス感染、免疫系の機能不全が潜在的な原因であることを認識しています。さらに、LRHLは男性でより一般的です。
性別と性別に関するメモ
セックスとジェンダーはスペクトル上に存在します。この記事では、出生時に割り当てられた性別を指すために「男性」、「女性」、またはその両方という用語を使用します。詳細については、ここをクリックしてください。
LRHL の診断には、同様の症状を伴う他の疾患を除外するための身体検査と血液検査が含まれる場合があります。ただし、リンパ節切除生検が、LRHL を患っているかどうかを判断する唯一の方法です。
医療チームは生検から採取した細胞を検査のために研究室に送ります。研究室では、免疫表現型検査を使用して、細胞表面のマーカーに基づいて特定の種類の細胞を識別し、LRHL を確認します。
診断後、医師は全身に広がるリンパ腫の重症度と範囲を調べるために、さらなる血液検査と画像検査を指示する場合があります。
治療は副作用を最小限に抑えながら可能な限り高い治癒率を達成することを目指します。治療計画は、病気の特定の段階と患者の全体的な健康状態を考慮して、高度に個別化されています。
治療戦略には次のようなものがあります。
- 化学療法:これは LRHL の第一選択治療であり、がん細胞を殺すか、がん細胞の増殖を止める薬が使用されます。患者は、1 つまたは複数の化学療法薬を経口投与または静脈または筋肉への注射によって投与されます。薬の選択と治療サイクルの長さは、病気の重症度とその人の健康状態によって異なります。
- 放射線療法:この治療法では、高エネルギーの光線または粒子を使用して、がん細胞を破壊したり、がん細胞の増殖を阻止します。 LRHLの場合、医師は病気が存在するリンパ節とその周囲の領域に放射線を照射します。医師は、初期段階の LRHL に対して放射線療法を使用することも、より進行した段階に対して化学療法と組み合わせて使用することもできます。
- 標的療法と免疫療法:これらの新しい治療法は、がん細胞の特定の側面を標的としたり、がんに対する体の免疫反応を強化したりするものです。
治療完了後は、患者の回復を監視し、再発の兆候を確認し、治療の長期的な影響を管理するために、定期的なフォローアップ訪問が不可欠です。
病気の原因が不明瞭であるため、LRHL に特化した既知の予防策はありません。ただし、健康的なライフスタイルと免疫システムを維持することは、一般的にリンパ腫の発症リスクを軽減するのに役立つ可能性があります。
LRHL と診断された人は、カウンセリング、サポート グループ、リソースを利用できます。リンパ腫研究財団や白血病・リンパ腫協会など、リンパ腫の研究と患者擁護に重点を置いている組織は、この病気に罹患している人々にとって、優れた情報源、精神的サポート、コミュニティの源となります。
リンパ球豊富なホジキンリンパ腫 (LRHL) は、ホジキンリンパ腫の異なるサブタイプであり、多くのリンパ球が存在することを特徴とします。医師は多くの場合、初期段階で診断します。
専門家はこの形態のリンパがんの原因については不明ですが、早期診断と適切な治療により良好な結果が得られる可能性があります。
リンパ球が豊富なホジキンリンパ腫について知っておくべきこと・関連動画
参考文献一覧
- https://www.lls.org/lymphoma/hodgkin-lymphoma/diagnosis/hodgkin-lymphoma-subtypes
- https://www.lls.org/lymphoma/hodgkin-lymphoma/signs-and-symptoms
- https://リンパ腫.org/resources/
- https://www.lls.org/support-resources
- https://www.lls.org/lymphoma/hodgkin-lymphoma/treatment
- https://www.ncbi.nlm.nih.gov/books/NBK499969/#article-22957.s8
- https://www.cancer.org/cancer/types/hodgkin-lymphoma/causes-risks-prevention/prevention.html
- https://www.ncbi.nlm.nih.gov/books/NBK499969/